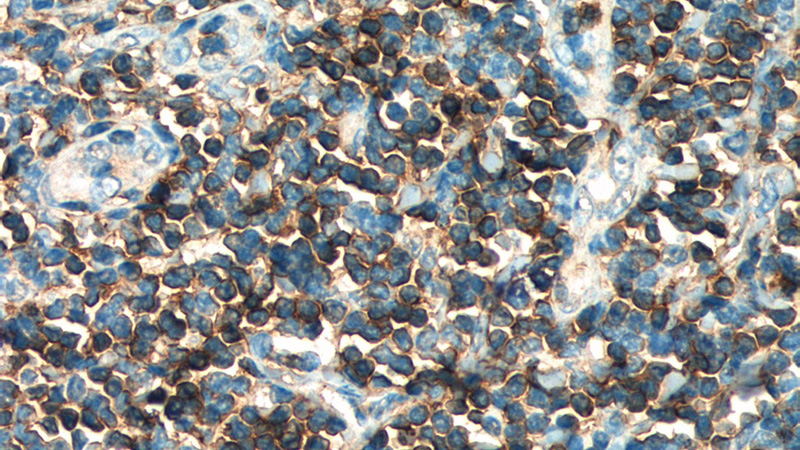
Immunohistochemistry of paraffin-embedded human tonsillitis tissue slide using Catalog No:107130(CD3G Antibody) at dilution of 1:400 (under 40x lens). heat mediated antigen retrieved with Sodium Citrate buffer (pH6).

-
Product Name
CD3 gamma antibody
- Documents
-
Description
CD3 gamma Mouse Monoclonal antibody. Positive IHC detected in human tonsillitis tissue. Positive WB detected in Jurkat cells. Observed molecular weight by Western-blot: 20-25 kDa
-
Tested applications
ELISA, WB, IHC
-
Species reactivity
Human; other species not tested.
-
Alternative names
CD3 gamma antibody; CD3G antibody; T cell receptor T3 gamma chain antibody; T3G antibody
-
Isotype
Mouse IgG2b
-
Preparation
This antibody was obtained by immunization of CD3 gamma recombinant protein (Accession Number: NM_000073). Purification method: Protein A purified.
-
Clonality
Monoclonal
-
Formulation
PBS with 0.02% sodium azide and 50% glycerol pH 7.3.
-
Storage instructions
Store at -20℃. DO NOT ALIQUOT
-
Applications
Recommended Dilution:
WB: 1:1000-1:10000
IHC: 1:50-1:500
-
Validations

Jurkat cells were subjected to SDS PAGE followed by western blot with Catalog No:107130(CD3G Antibody) at dilution of 1:4000

Immunohistochemistry of paraffin-embedded human tonsillitis tissue slide using Catalog No:107130(CD3G Antibody) at dilution of 1:400 (under 10x lens). heat mediated antigen retrieved with Sodium Citrate buffer (pH6).
Immunohistochemistry of paraffin-embedded human tonsillitis tissue slide using Catalog No:107130(CD3G Antibody) at dilution of 1:400 (under 40x lens). heat mediated antigen retrieved with Sodium Citrate buffer (pH6).
-
Background
CD3 is a complex of proteins that directly associates with the T cell receptor (TCR). The TCR/CD3 complex of T-lymphocytes consists of either a TCR alpha/beta or TCR gamma/delta heterodimer coexpressed at the cell surface with the invariant subunits of CD3 labeled gamma, delta, epsilon, zeta, and eta. The TCR recognizes antigens bound to major histocompatibility complex (MHC) molecules. TCR-mediated peptide-MHC recognition is transmitted to the CD3 complex, leading to the intracellular signal transduction. CD3 is considered to be a pan-T cell marker for detection of normal and neoplastic T cells.
Related Products / Services
Please note: All products are "FOR RESEARCH USE ONLY AND ARE NOT INTENDED FOR DIAGNOSTIC OR THERAPEUTIC USE"
